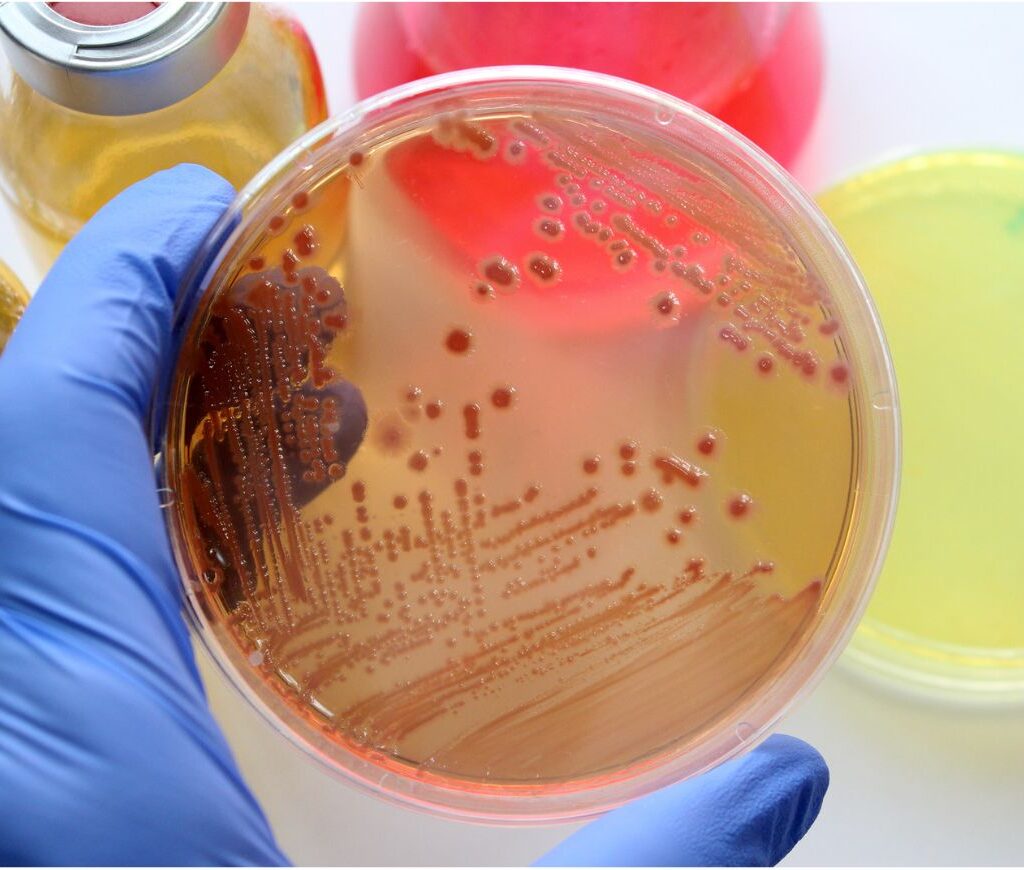
exame toxicológico

EXAME TOXICOLÓGICO
// toxicologico
Sonolayer: Segurança e Confiança Através do Exame Toxicológico
Na Sonolayer, Centro de Diagnósticos, acreditamos que a saúde e a segurança são pilares fundamentais para o bem-estar individual e coletivo. Por isso, oferecemos o exame toxicológico, um procedimento crucial para a prevenção do uso de drogas, a promoção da saúde no trabalho e a garantia de um trânsito mais seguro.
Mas afinal, o que é o exame toxicológico e por que ele é tão importante?
O exame toxicológico é uma análise laboratorial que detecta a presença de drogas e outras substâncias psicoativas no organismo. Ele pode ser realizado por diversos motivos, como:
- Obtenção ou renovação da Carteira Nacional de Habilitação (CNH) nas categorias C, D e E;
- Admissão e desligamento de funcionários em empresas que exigem o exame;
- Acompanhamento de tratamento de dependência química;
- Exigência em processos judiciais;
- Prevenção do uso de drogas no ambiente de trabalho ou familiar.
Quais são os benefícios do exame toxicológico?
O exame toxicológico oferece diversos benefícios, entre os quais podemos destacar:
- Maior segurança no trânsito: ao detectar o uso de drogas por motoristas profissionais, o exame contribui para a redução de acidentes e para a segurança de todos nas estradas.
- Ambiente de trabalho mais saudável: o exame toxicológico pode prevenir o uso de drogas no ambiente de trabalho, promovendo um ambiente mais seguro, produtivo e colaborativo.
- Melhora na qualidade de vida: a detecção precoce do uso de drogas permite a intervenção imediata e o início do tratamento adequado, contribuindo para a melhora da qualidade de vida do indivíduo e de seus familiares.
- Prevenção de doenças: o uso de drogas pode levar a diversas doenças graves, como HIV/AIDS, hepatites e problemas respiratórios. O exame toxicológico pode ajudar a prevenir essas doenças ao detectar o uso de drogas precocemente.
O que é o exame toxicológico?
O exame toxicológico, também conhecido como exame do cabelo, é um procedimento realizado para detectar o uso de drogas ilícitas nos últimos 90 a 180 dias. Ele é frequentemente solicitado para motoristas profissionais que desejam obter ou renovar a CNH nas categorias C, D e E, mas também pode ser solicitado em outras situações, como em concursos públicos, processos trabalhistas e exigências de empresas.

Como é feito o exame toxicológico?
O exame toxicológico é um processo simples, rápido e indolor. A coleta da amostra pode ser feita em um laboratório ou em um local autorizado pelo laboratório. Veja como funciona:
- Coleta da amostra: Uma pequena mecha de cabelo (cerca da espessura de uma caneta) é cortada rente ao couro cabeludo. Se você não tiver cabelo suficiente, a amostra pode ser coletada de pelos pubianos ou axilares.
- Identificação: A amostra é identificada com seus dados pessoais e enviada para o laboratório.
- Análise: No laboratório, a amostra é analisada em busca de substâncias psicoativas, como maconha, cocaína, anfetaminas, metanfetaminas, ecstasy, heroína e outras.
- Resultado: O resultado do exame é geralmente disponibilizado em até 48 horas. Você receberá um laudo com a informação de quais substâncias foram encontradas, em quais concentrações e o período de detecção.
A Sonolayer realiza o exame toxicológico?
Sim, o Sonolayer realiza o exame toxicológico com qualidade e rapidez. Contamos com 3 unidades de atendimento, em Guarulhos, Mogi das Cruzes e Santo André.
Na Sonolayer, você encontra:
- Profissionais qualificados e experientes: nossa equipe é altamente capacitada para realizar o exame toxicológico com total segurança e confiabilidade.
- Tecnologia de ponta: utilizamos equipamentos modernos e técnicas avançadas para garantir a precisão dos resultados do exame.
- Ambiente acolhedor e sigilo absoluto: prezamos pelo bem-estar de nossos pacientes e garantimos a confidencialidade dos resultados do exame.
Nossas Unidades:
Unidade Análises Clínicas – Guarulhos
Avenida Salgado Filho, 240 – Centro – Guarulhos – SP
Tel: (11) 2713-6400
Unidade Santo André
Av. Giovanni Batista Pirelli, 155, Loja 327, Vila Homero Thon, Santo André, SP, CEP: 09111-340
Atrium Shopping Santo André
Tel.:(11) 3135-4662
Unidade Mogi das Cruzes
Avenida Vereador Narciso Yague Guimarães, 1000, Centro Cívico, Mogi das Cruzes, SP, CEP: 08780-000
Supermercado Davó
Central de Agendamento: (11) 2713-6400
WhatsApp: (11) 93958-8780
Visite nosso site e saiba mais: https://www.sonolayer.com.br/
